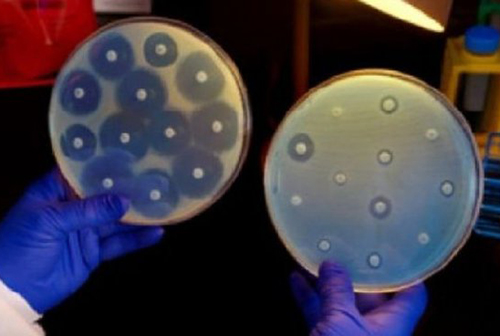

jquery carousel by WOWSlider.com v8.8
Статьи




















Новости